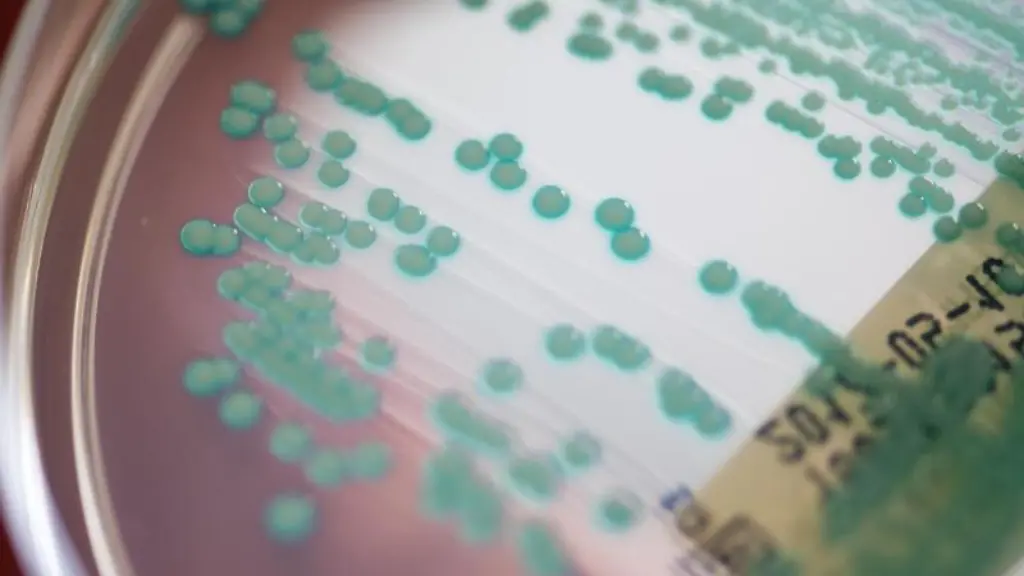
Eine-petrischale-mit-Keimen

BayernMultiresistente Keime: Behörde spricht von stabiler Lage
Erlangen (dpa/lby) - Im Kampf gegen multiresistente Keime ist der Freistaat einer Resistenz-Auswertung zufolge gut aufgestellt. In Bayern zeige sich eine weiterhin gute und stabile Resistenzlage, die Therapiemöglichkeiten für bakterielle Infektionskrankheiten mit Antibiotika seien weiter gesichert, teilte das Landesamt für Gesundheit und Lebensmittelsicherheit (LGL) in Erlangen am Donnerstag mit. Das gehe aus der Auswertung der Bayerischen Antibiotikaresistenz-Datenbank (Barda) für das Jahr 2020 hervor.
Dafür waren im vergangenen Jahr 414.286 anonymisierte Resistenztests aus Intensiv- und Pflegestationen sowie von Arztpraxen auf elf ausgewählte Erreger untersucht worden. Die jährlichen Auswertungen dienten der Beobachtung, um bei Resistenzen rechtzeitig gegensteuern zu können, sagte ein LGL-Sprecher.
Ein positives Beispiel: Die laut LGL nach wie vor niedrigen Resistenzraten von "Staphylococcus aureus". Das Bakterium könne vor allem Haut- und Wundinfektionen hervorrufen. Bei der Auswertung 2020 ergaben sich Resistenzraten gegen das Antibiotikum Oxacillin von deutlich unter zehn Prozent. Anfang der 2010er-Jahre seien es noch rund 20 Prozent gewesen, sagte der Sprecher.
Weiterhin genauer Beobachtung bedürfe dagegen "Enterococcus faecium", das Harnwegsinfektionen, Blutvergiftung oder eine Entzündung der Herzinnenhaut auslösen kann, sagte LGL-Präsident Walter Jonas. "Es muss auch weiterhin unser aller Ziel sein, die Resistenzraten weiter zu senken."
© dpa-infocom, dpa:210729-99-604947/3